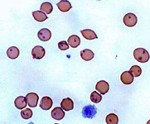

Другие названия и синонимы
Ureaplasmosis in women.
МКБ-10 коды
|
|
Описание
Уреаплазмоз у женщин. Инфекционное воспалительное заболевание мочеполовых органов, вызванное патологической активностью уреаплазм. В 70-80% случаев заболевание протекает в форме бессимптомного носительства. Может проявляться неспецифическими дизурическими симптомами, увеличением количества прозрачных влагалищных выделений, тянущими болями в нижней части живота и нарушением репродуктивной функции. Для постановки диагноза используют бактериальный посев, ПЦР, ИФА, ПИФ. Этиотропное лечение предполагает назначение антибактериальных препаратов - макролидов, тетрациклинов и фторхинолонов.

Дополнительные факты
Впервые уреаплазма была выделена у пациента негонококковым уретритом в 1954 году. На сегодняшний день возбудитель считается условно-патогенным микроорганизмом, проявляющим патологическую активность только при наличии определённых факторов. Носительницами бактерий являются 40-50% сексуально активных здоровых женщин. Микроорганизм выявляется на половых органах у каждой третьей новорожденной девочки и у 5-22% школьниц, которые не живут половой жизнью. Хотя по результатам различных исследований уреаплазмы были единственными микроорганизмами, обнаруженными у части пациенток с бесплодием и хроническими заболеваниями урогенитальной сферы, уреаплазмоз не внесен как самостоятельное заболевание в действующую Международную Классификацию Болезней.
Причины
Возбудителем заболевания является уреаплазма - внутриклеточная бактерия без собственной клеточной мембраны, обладающая тропностью к цилиндрическому эпителию мочеполовых органов. Из 6 существующих видов уреаплазм патогенная активность выявлена у двух - Ureaplasma urealyticum и Ureaplasma parvum. Заражение происходит при незащищённом половом контакте или во время родов. Убедительных доказательств о контактно-бытовом способе передачи уреаплазмоза на сегодняшний день не существует.
В большинстве случаев носительство уреаплазм является бессимптомным. Основными факторами, способствующими развитию воспалительного процесса, являются:
• Дисгормональные состояния. Возбудитель может проявлять патогенную активность во время беременности, при нарушении эндокринной функции яичников.
• Снижение иммунитета. Воспаление урогенитального тракта чаще возникает у женщин при заболеваниях, снижающих иммунитет, и на фоне приёма иммуносупрессивных препаратов (при лечении онкопатологии).
• Вагинальный дисбактериоз. Нарушение нормальной микрофлоры влагалища при нерациональной антибактериальной терапии и гормональном дисбалансе активирует условно-патогенные микроорганизмы, в том числе уреаплазмы.
• Инвазивные вмешательства. Пусковым моментом для развития уреаплазмоза в ряде случаев становятся аборты, инструментальные лечебно-диагностические процедуры (гистероскопия, уретро- и цистоскопия, хирургические методы лечения эрозии шейки матки и тд ).
• Частая смена половых партнёров. Бактерия активируется в ассоциации с другими возбудителями ИППП, проникающими в половые органы женщины во время незащищённого секса со случайными партнёрами.
В большинстве случаев носительство уреаплазм является бессимптомным. Основными факторами, способствующими развитию воспалительного процесса, являются:
• Дисгормональные состояния. Возбудитель может проявлять патогенную активность во время беременности, при нарушении эндокринной функции яичников.
• Снижение иммунитета. Воспаление урогенитального тракта чаще возникает у женщин при заболеваниях, снижающих иммунитет, и на фоне приёма иммуносупрессивных препаратов (при лечении онкопатологии).
• Вагинальный дисбактериоз. Нарушение нормальной микрофлоры влагалища при нерациональной антибактериальной терапии и гормональном дисбалансе активирует условно-патогенные микроорганизмы, в том числе уреаплазмы.
• Инвазивные вмешательства. Пусковым моментом для развития уреаплазмоза в ряде случаев становятся аборты, инструментальные лечебно-диагностические процедуры (гистероскопия, уретро- и цистоскопия, хирургические методы лечения эрозии шейки матки и тд ).
• Частая смена половых партнёров. Бактерия активируется в ассоциации с другими возбудителями ИППП, проникающими в половые органы женщины во время незащищённого секса со случайными партнёрами.
Патогенез
Патогенез уроплазмоза у женщин основан на адгезивно-инвазивных и ферментообразующих свойствах микроорганизма. При попадании на слизистую мочеполовых органов бактерия прикрепляется к оболочке клетки цилиндрического эпителия, сливается с ней и проникает в цитоплазму, где и происходит её размножение. Микроорганизм продуцирует особый фермент, который расщепляет иммуноглобулин А, снижая таким образом иммунный ответ на инфекцию. При бессимптомном течении местные воспалительные и деструктивные изменения выражены слабо. Повышение патогенной активности возбудителя под действием провоцирующих факторов приводит к развитию воспаления - сосудистой реакции, повышению тканевой проницаемости, разрушению эпителиальных клеток.
Классификация
Основными критериями выделения клинических форм уреаплазмоза у женщин являются характер течения и степень выраженности патологических проявлений. В частности, специалисты в области гинекологии различают:
• Носительство уреаплазм. У большинства женщин, при обследовании которых выявляется этот микроорганизм, никаких признаков воспалительных процессов нет.
• Острый уреаплазмоз. Наблюдается крайне редко, сопровождается клинически выраженными признаками поражения мочеполовых органов и общей интоксикацией.
• Хронический уреаплазмоз. Признаки острого воспаления отсутствуют или проявляются периодически при наличии провоцирующих факторов, возможны нарушения репродуктивной функции и хроническое воспаление органов урогенительного тракта.
• Носительство уреаплазм. У большинства женщин, при обследовании которых выявляется этот микроорганизм, никаких признаков воспалительных процессов нет.
• Острый уреаплазмоз. Наблюдается крайне редко, сопровождается клинически выраженными признаками поражения мочеполовых органов и общей интоксикацией.
• Хронический уреаплазмоз. Признаки острого воспаления отсутствуют или проявляются периодически при наличии провоцирующих факторов, возможны нарушения репродуктивной функции и хроническое воспаление органов урогенительного тракта.
Клиническая картина
В 70-80% случаев какие-либо клинические проявления, свидетельствующие об инфицировании организма уреаплазмами, отсутствуют. Заболевание не имеет специфических симптомов и в периоды обострений проявляется признаками, характерными для воспалительных процессов в мочеполовой системе. Женщина может жаловаться дискомфорт, рези, жжение, болезненные ощущения при мочеиспускании. Несколько увеличивается объём прозрачных влагалищных выделений. При восходящем развитии инфекции с поражением внутренних репродуктивных органов могут беспокоить ноющие или тянущие боли в нижней части живота. При остром течении и в периоды обострений температура повышается до субфебрильных цифр, пациентка отмечает слабость, утомляемость, снижение работоспособности. О хроническом уреаплазмозе могут свидетельствовать стойкие к лечению уретриты, вагиниты, эндоцервициты, аднекситы, невозможность забеременеть, самопроизвольное прерывание или патологическое течение беременности.
Ассоциированные симптомы: Болезненное мочеиспускание. Боль в гениталиях у женщин. Боль в паху у женщин. Боль в промежности у женщин. Боль во влагалище. Выделения из влагалища (бели). Гнойные выделения из влагалища. Зуд. Зуд в интимной зоне у женщин. Зуд во влагалище. Зуд вульвы. Редкие месячные. Рези при мочеиспускании у женщин. Серые выделения из влагалища. Скудные месячные.
Ассоциированные симптомы: Болезненное мочеиспускание. Боль в гениталиях у женщин. Боль в паху у женщин. Боль в промежности у женщин. Боль во влагалище. Выделения из влагалища (бели). Гнойные выделения из влагалища. Зуд. Зуд в интимной зоне у женщин. Зуд во влагалище. Зуд вульвы. Редкие месячные. Рези при мочеиспускании у женщин. Серые выделения из влагалища. Скудные месячные.
Возможные осложнения
При длительном течении уреаплазмоз у женщин осложняется хроническими воспалительными процессами в матке и придатках, которые приводят к бесплодию, выкидышам и преждевременным родам. Ситуация усугубляется инфицированием партнёра, у которого на фоне заболевания может развиться мужское бесплодие. В некоторых случаях воспаление, сосудистые и аутоиммунные процессы в эндометрии становятся причиной первичной плацентарной и вторичной фетоплацентарной недостаточности с нарушением нормального развития плода, риском возникновения аномалий и повышением перинатальной заболеваемости. Поскольку беременность является провоцирующим фактором для активации микроорганизма, а лечение инфекционного заболевания предусматривает назначение препаратов, способных влиять на плод, при репродуктивном планировании важно своевременно выявить возбудителя.
|
|
Диагностика
Данные влагалищного осмотра, бимануального обследования и клиническая картина заболевания неспецифичны и, как правило, свидетельствуют о наличии воспалительного процесса. Поэтому ключевую роль в диагностике уреаплазмоза у женщин играют специальные методы исследования, позволяющие обнаружить возбудителя:
• Бак. посев на уреаплазму. При посеве биоматериала (выделений, мазков) на питательную среду выявляются колонии уреаплазм, после чего определяется их чувствительность к антибактериальным препаратам.
• ПЦР. С помощью полимеразной цепной реакции в биоматериале пациентки в течение суток можно обнаружить генетический материал возбудителя.
• Серологическое исследование. В ходе иммунофлюоресцентного анализа (ИФА) и при прямой флюоресценции (ПИФ) в крови женщины обнаруживаются антитела к бактерии, определяется их титр.
При дифференциальной диагностике необходимо исключить инфицирование другими возбудителями - хламидиями, трихомонадами, гонококками, микоплазмами и тд Основанием для постановки диагноза уреаплазмоза является наличие воспалительных процессов в мочеполовых органах женщины при отсутствии каких-либо других возбудителей ИППП, кроме уреаплазм. Наряду с гинекологом, к консультированию пациентки привлекают уролога.
• Бак. посев на уреаплазму. При посеве биоматериала (выделений, мазков) на питательную среду выявляются колонии уреаплазм, после чего определяется их чувствительность к антибактериальным препаратам.
• ПЦР. С помощью полимеразной цепной реакции в биоматериале пациентки в течение суток можно обнаружить генетический материал возбудителя.
• Серологическое исследование. В ходе иммунофлюоресцентного анализа (ИФА) и при прямой флюоресценции (ПИФ) в крови женщины обнаруживаются антитела к бактерии, определяется их титр.
При дифференциальной диагностике необходимо исключить инфицирование другими возбудителями - хламидиями, трихомонадами, гонококками, микоплазмами и тд Основанием для постановки диагноза уреаплазмоза является наличие воспалительных процессов в мочеполовых органах женщины при отсутствии каких-либо других возбудителей ИППП, кроме уреаплазм. Наряду с гинекологом, к консультированию пациентки привлекают уролога.
Лечение
Ключевыми задачами терапии при уреаплазменной инфекции являются уменьшение воспаления, восстановление иммунитета и нормальной влагалищной микрофлоры. Пациенткам с клиническими признаками уреаплазмоза рекомендованы:
• Этиотропная антибиотикотерапия. При выборе препарата необходимо учитывать чувствительность возбудителя. Обычно назначают 1-2-недельный курс тетрациклинов, макролидов, фторхинолонов.
• Санация влагалища. Введение свечей с антибиотиком и противогрибковым препаратом дополняет антибактериальное лечение.
• Иммунотерапия. Для восстановления иммунитета показаны иммуномодулирующие и иммуностимулирующие средства, в том числе растительного происхождения.
• Нормализация микробиоценоза влагалища. Применение пробиотиков местно и внутрь позволяет восстановить вагинальную микрофлору, которая угнетает патологическую активность уреаплазм.
• Ферментные препараты. Энзимы оказывают противовоспалительный эффект и усиливают процессы регенерации тканей.
• Витаминотерапия. С общеукрепляющей целью в комплексном лечении уреаплазмоза у женщин используют мультивитаминные и витаминно-минеральные комплексы.
Важно отметить, что показания для назначения этиотропного противоуреаплазменного лечения ограничены. Как правило, антибиотики применяют при обнаружении уреаплазм у пациенток с устойчивыми к лечению хроническими воспалительными процессами и нарушениями репродуктивной функции при отсутствии других возбудителей ИППП. Также антибактериальный курс рекомендован носительницам уреаплазмы, которые планируют беременность.
• Этиотропная антибиотикотерапия. При выборе препарата необходимо учитывать чувствительность возбудителя. Обычно назначают 1-2-недельный курс тетрациклинов, макролидов, фторхинолонов.
• Санация влагалища. Введение свечей с антибиотиком и противогрибковым препаратом дополняет антибактериальное лечение.
• Иммунотерапия. Для восстановления иммунитета показаны иммуномодулирующие и иммуностимулирующие средства, в том числе растительного происхождения.
• Нормализация микробиоценоза влагалища. Применение пробиотиков местно и внутрь позволяет восстановить вагинальную микрофлору, которая угнетает патологическую активность уреаплазм.
• Ферментные препараты. Энзимы оказывают противовоспалительный эффект и усиливают процессы регенерации тканей.
• Витаминотерапия. С общеукрепляющей целью в комплексном лечении уреаплазмоза у женщин используют мультивитаминные и витаминно-минеральные комплексы.
Важно отметить, что показания для назначения этиотропного противоуреаплазменного лечения ограничены. Как правило, антибиотики применяют при обнаружении уреаплазм у пациенток с устойчивыми к лечению хроническими воспалительными процессами и нарушениями репродуктивной функции при отсутствии других возбудителей ИППП. Также антибактериальный курс рекомендован носительницам уреаплазмы, которые планируют беременность.
Прогноз
Прогноз уреаплазмоза у женщин благоприятный. Этиотропное лечение позволяет полностью избавиться от бактерии, однако из-за отсутствия пассивного иммунитета и высокой распространённости возбудителя возможно повторное заражение.
Профилактика
Поскольку уреаплазма является условно-патогенным микроорганизмом, для профилактики воспаления важны рациональный режим сна и отдыха, сезонное поддержание иммунитета, обоснованное назначение инвазивных методов диагностики и лечения заболеваний женской половой сферы, использование барьерной контрацепции. Для предупреждения патологической активации возбудителя во время планируемой беременности женщинам с носительством уреаплазм рекомендована профилактическая антибиотикотерапия.